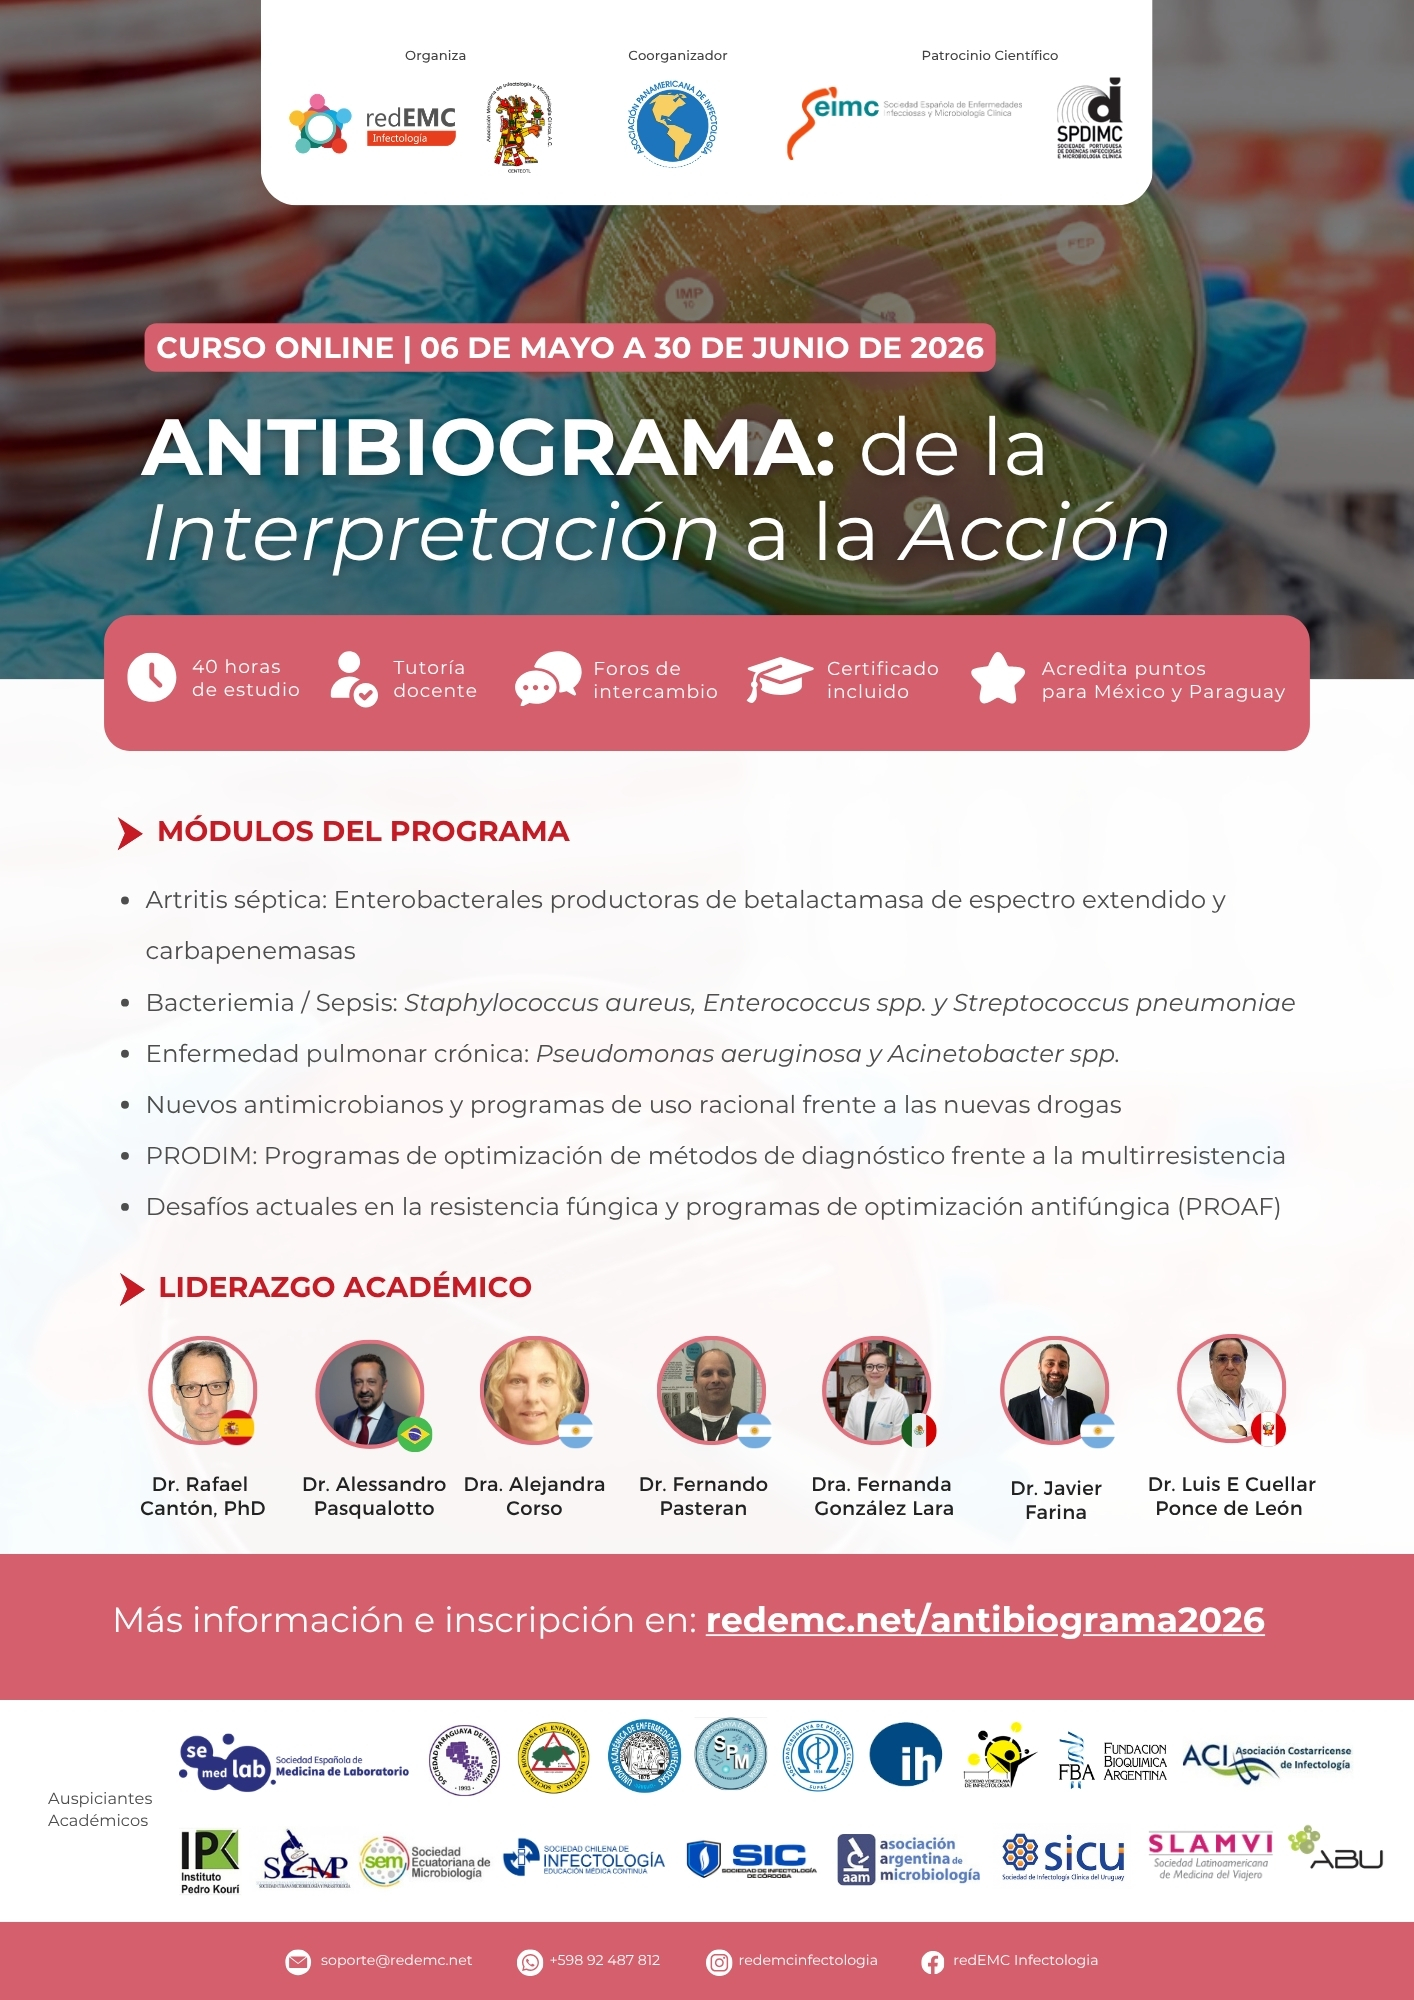
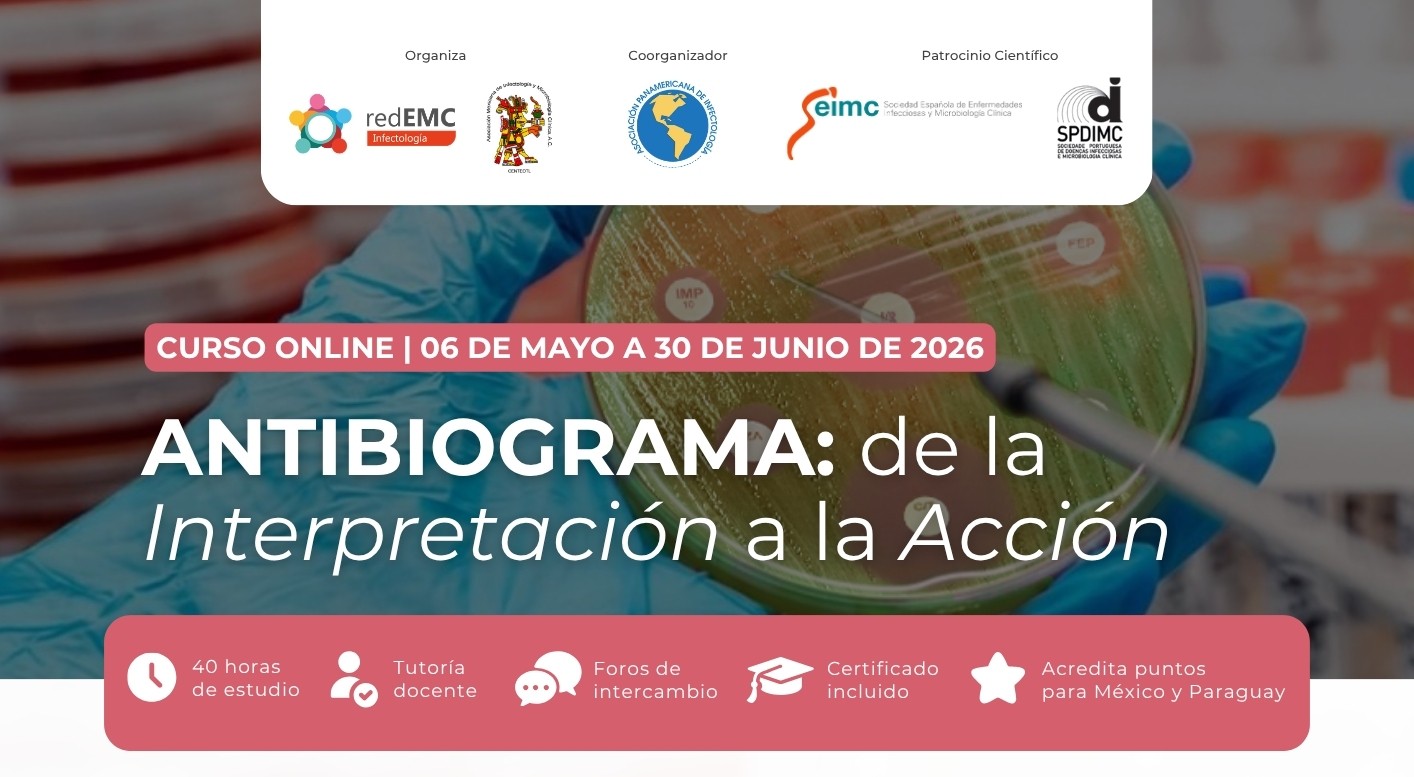

El Instituto de Higiene invita a docentes y estudiantes a participar del curso online “Antibiograma: de la interpretación a la acción”, una propuesta de formación actualizada en el abordaje de la resistencia antimicrobiana y la toma de decisiones clínicas basadas en resultados microbiológicos.
El curso se desarrollará del 6 de mayo al 30 de junio de 2026, con una duración total de 8 semanas, bajo modalidad virtual, lo que permite a los participantes acceder a los contenidos en el día y horario que les resulte más conveniente.
La propuesta aborda temáticas clave como infecciones por bacterias multirresistentes, interpretación clínica del antibiograma, nuevos antimicrobianos y programas de optimización del uso de antibióticos, entre otros.
Beneficio para la comunidad del Instituto de Higiene
Docentes y estudiantes del Instituto acceden a un precio bonificado de UYU $6.992, seleccionando la institución en el formulario de inscripción.
 Más información e inscripciones: redemc.net/antibiograma2026
Más información e inscripciones: redemc.net/antibiograma2026
Información importante para cursantes
- Los contenidos estarán disponibles a partir del día de inicio del curso.
- El día de apertura recibirán un correo de bienvenida del equipo docente con indicaciones para comenzar.
- Cada miércoles se habilitará un nuevo módulo temático durante las 8 semanas.
- Para obtener el certificado será necesario completar al menos 5 módulos dentro del período del curso; en caso contrario se otorgará constancia de participación.
- Los materiales permanecerán disponibles una vez finalizada la cursada.